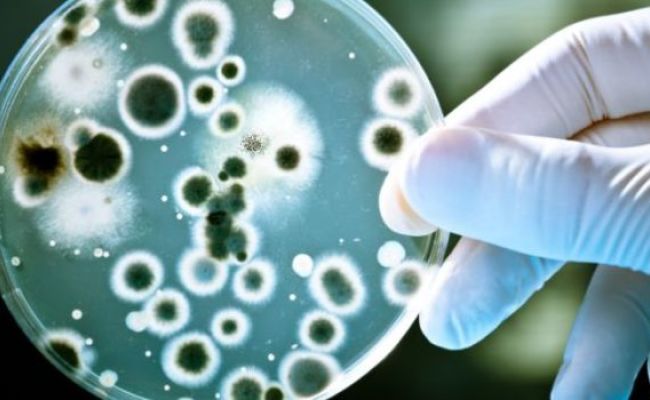
Mumbai Records Three Deaths Through Leptospirosis In A Week: Causes And Symptoms Of Leptospirosis

Leptospirosis
-
{
- All
- News
- Videos
- Web Stories
-

Over 3,000 Leptospirosis Cases, 209 Deaths Reported In Kerala In 2025: J P Nadda
- Saturday December 13, 2025
- Health | Press Trust of India
Thiruvananthapuram recorded 583 cases, the highest among the 14 districts in Kerala, followed by Ernakulam at 492 and Thrissur at 340, Nadda said in response to a query.
-
 www.ndtv.com
www.ndtv.com
-

Mumbai Rains Red Alert: Beware Of Leptospirosis, Follow These Prevention Tips
- Tuesday August 19, 2025
- Health | Written by Varsha Vats
Leptospirosis primarily spreads through contaminated water or soil. During heavy rainfall, the urine or body fluids of infected animals can easily contaminate both.
-
 www.ndtv.com
www.ndtv.com
-

Explained: What Is Leptospirosis, Rare Disease Affecting Bhagwant Mann
- Sunday September 29, 2024
- India News | Indo-Asian News Service
Leptospirosis is an extremely rare bacterial disease that spreads to humans via the urine of infected animals like dogs, and rats, said an expert on Saturday, after Punjab Chief Minister Bhagwant Mann was diagnosed with the condition.
-
 www.ndtv.com
www.ndtv.com
-

You May Be Prone To Leptospirosis During Monsoon; Here's How To Prevent It
- Wednesday July 19, 2023
- Health | Manya Singh
Humans can become infected with Leptospira when they come into contact with water, soil, or food contaminated with the urine of infected animals. Here's how you can prevent it.
-
 www.ndtv.com
www.ndtv.com
-

Leptospirosis Kills 12 In Kerala: Here's How And All That You Need To Know
- Tuesday September 4, 2018
- Health | DoctorNDTV
Flood-hit Kerala is now facing the aftermath of the natural disaster. It is currently hit with leptospirosis or rat fever, which is a bacterial infection which spreads through the urine of infected animals.
-
 www.ndtv.com
www.ndtv.com
-

'Rat Fever' Cases Rise After Kerala Floods, 12 Dead Since August 1
- Monday September 3, 2018
- Kerala News | Reported by Sneha Mary Koshy, Edited by Swati Bhasin
Twelve people have died in Kerala since August, six of them in the last three days, due to the waterborne disease leptospirosis, locally known as 'rat fever'. The disease is not new to the state. Between January and July, Leptospirosis claimed 28 lives. But a spurt in the cases has been observed since the worst floods in a century hit the state on ...
-
 www.ndtv.com
www.ndtv.com
-

Kerala Government Issues Alert After Water Borne Disease Claim 7 Lives
- Sunday September 2, 2018
- India News | Press Trust of India
Outbreak of water borne diseases in Kerala have claimed seven lives since August 29, prompting the state government to issue an alert to the people to maintain extra vigil.
-
 www.ndtv.com
www.ndtv.com
-

This Monsoon, Stay Away From Leptospirosis: Here's How
- Wednesday July 25, 2018
- Health | DoctorNDTV
Leptospirosis is a common infection during monsoon. It primarily occurs because of exposure todirty environment and unhygienic surroundings. Urine of infected animals like dogs, wild rats, rodents can also cause Leptospirosis.
-
 www.ndtv.com
www.ndtv.com
-

Mumbai Records Three Deaths Through Leptospirosis In A Week: Causes And Symptoms Of Leptospirosis
- Monday July 2, 2018
- Health | DoctorNDTV
Leptospirosis is a water-borne bacterial disease that has possibly causes the death of 3 in Mumbai. Were you aware of these causes, symptoms, prevention and treatment techniques for leptospirosis?
-
 www.ndtv.com
www.ndtv.com
-

In Mumbai, Leptospirosis Killed More People Than Dengue In September
- Wednesday October 12, 2016
Mumbai: Mumbai has witnessed more deaths due to leptospirosis-related complications that to dengue in September. While two people died of dengue last month, deaths due to leptospirosis were more than three times. Leptospirosis is an infection that gets transmitted to humans when open wounds or broken skin comes in contact with water infected by ani...
-
 everylifecounts.ndtv.com
everylifecounts.ndtv.com
-

Court Seeks Mumbai Civic Body's Response On Steps Taken To Tackle Swine Flu
- Friday April 22, 2016
- Mumbai News | Press Trust of India
The Bombay High Court today asked the Municipal Corporation of Greater Mumbai (MCGM) to file a reply to a petition by June 7 on steps taken by it to tackle vector-borne and water-borne diseases including leptospirosis, H1N1, dengue, swine flu and malaria.
-
 www.ndtv.com
www.ndtv.com
-

12 Die of Leptospirosis in Mumbai
- Wednesday July 8, 2015
- Mumbai News | Press Trust of India
Twelve people have died of leptospirosis infection in the city in the last seven days, a civic official said today.
-
 www.ndtv.com
www.ndtv.com
-

Over 3,000 Leptospirosis Cases, 209 Deaths Reported In Kerala In 2025: J P Nadda
- Saturday December 13, 2025
- Health | Press Trust of India
Thiruvananthapuram recorded 583 cases, the highest among the 14 districts in Kerala, followed by Ernakulam at 492 and Thrissur at 340, Nadda said in response to a query.
-
 www.ndtv.com
www.ndtv.com
-

Mumbai Rains Red Alert: Beware Of Leptospirosis, Follow These Prevention Tips
- Tuesday August 19, 2025
- Health | Written by Varsha Vats
Leptospirosis primarily spreads through contaminated water or soil. During heavy rainfall, the urine or body fluids of infected animals can easily contaminate both.
-
 www.ndtv.com
www.ndtv.com
-

Explained: What Is Leptospirosis, Rare Disease Affecting Bhagwant Mann
- Sunday September 29, 2024
- India News | Indo-Asian News Service
Leptospirosis is an extremely rare bacterial disease that spreads to humans via the urine of infected animals like dogs, and rats, said an expert on Saturday, after Punjab Chief Minister Bhagwant Mann was diagnosed with the condition.
-
 www.ndtv.com
www.ndtv.com
-

You May Be Prone To Leptospirosis During Monsoon; Here's How To Prevent It
- Wednesday July 19, 2023
- Health | Manya Singh
Humans can become infected with Leptospira when they come into contact with water, soil, or food contaminated with the urine of infected animals. Here's how you can prevent it.
-
 www.ndtv.com
www.ndtv.com
-

Leptospirosis Kills 12 In Kerala: Here's How And All That You Need To Know
- Tuesday September 4, 2018
- Health | DoctorNDTV
Flood-hit Kerala is now facing the aftermath of the natural disaster. It is currently hit with leptospirosis or rat fever, which is a bacterial infection which spreads through the urine of infected animals.
-
 www.ndtv.com
www.ndtv.com
-

'Rat Fever' Cases Rise After Kerala Floods, 12 Dead Since August 1
- Monday September 3, 2018
- Kerala News | Reported by Sneha Mary Koshy, Edited by Swati Bhasin
Twelve people have died in Kerala since August, six of them in the last three days, due to the waterborne disease leptospirosis, locally known as 'rat fever'. The disease is not new to the state. Between January and July, Leptospirosis claimed 28 lives. But a spurt in the cases has been observed since the worst floods in a century hit the state on ...
-
 www.ndtv.com
www.ndtv.com
-

Kerala Government Issues Alert After Water Borne Disease Claim 7 Lives
- Sunday September 2, 2018
- India News | Press Trust of India
Outbreak of water borne diseases in Kerala have claimed seven lives since August 29, prompting the state government to issue an alert to the people to maintain extra vigil.
-
 www.ndtv.com
www.ndtv.com
-

This Monsoon, Stay Away From Leptospirosis: Here's How
- Wednesday July 25, 2018
- Health | DoctorNDTV
Leptospirosis is a common infection during monsoon. It primarily occurs because of exposure todirty environment and unhygienic surroundings. Urine of infected animals like dogs, wild rats, rodents can also cause Leptospirosis.
-
 www.ndtv.com
www.ndtv.com
-

Mumbai Records Three Deaths Through Leptospirosis In A Week: Causes And Symptoms Of Leptospirosis
- Monday July 2, 2018
- Health | DoctorNDTV
Leptospirosis is a water-borne bacterial disease that has possibly causes the death of 3 in Mumbai. Were you aware of these causes, symptoms, prevention and treatment techniques for leptospirosis?
-
 www.ndtv.com
www.ndtv.com
-

In Mumbai, Leptospirosis Killed More People Than Dengue In September
- Wednesday October 12, 2016
Mumbai: Mumbai has witnessed more deaths due to leptospirosis-related complications that to dengue in September. While two people died of dengue last month, deaths due to leptospirosis were more than three times. Leptospirosis is an infection that gets transmitted to humans when open wounds or broken skin comes in contact with water infected by ani...
-
 everylifecounts.ndtv.com
everylifecounts.ndtv.com
-

Court Seeks Mumbai Civic Body's Response On Steps Taken To Tackle Swine Flu
- Friday April 22, 2016
- Mumbai News | Press Trust of India
The Bombay High Court today asked the Municipal Corporation of Greater Mumbai (MCGM) to file a reply to a petition by June 7 on steps taken by it to tackle vector-borne and water-borne diseases including leptospirosis, H1N1, dengue, swine flu and malaria.
-
 www.ndtv.com
www.ndtv.com
-

12 Die of Leptospirosis in Mumbai
- Wednesday July 8, 2015
- Mumbai News | Press Trust of India
Twelve people have died of leptospirosis infection in the city in the last seven days, a civic official said today.
-
 www.ndtv.com
www.ndtv.com